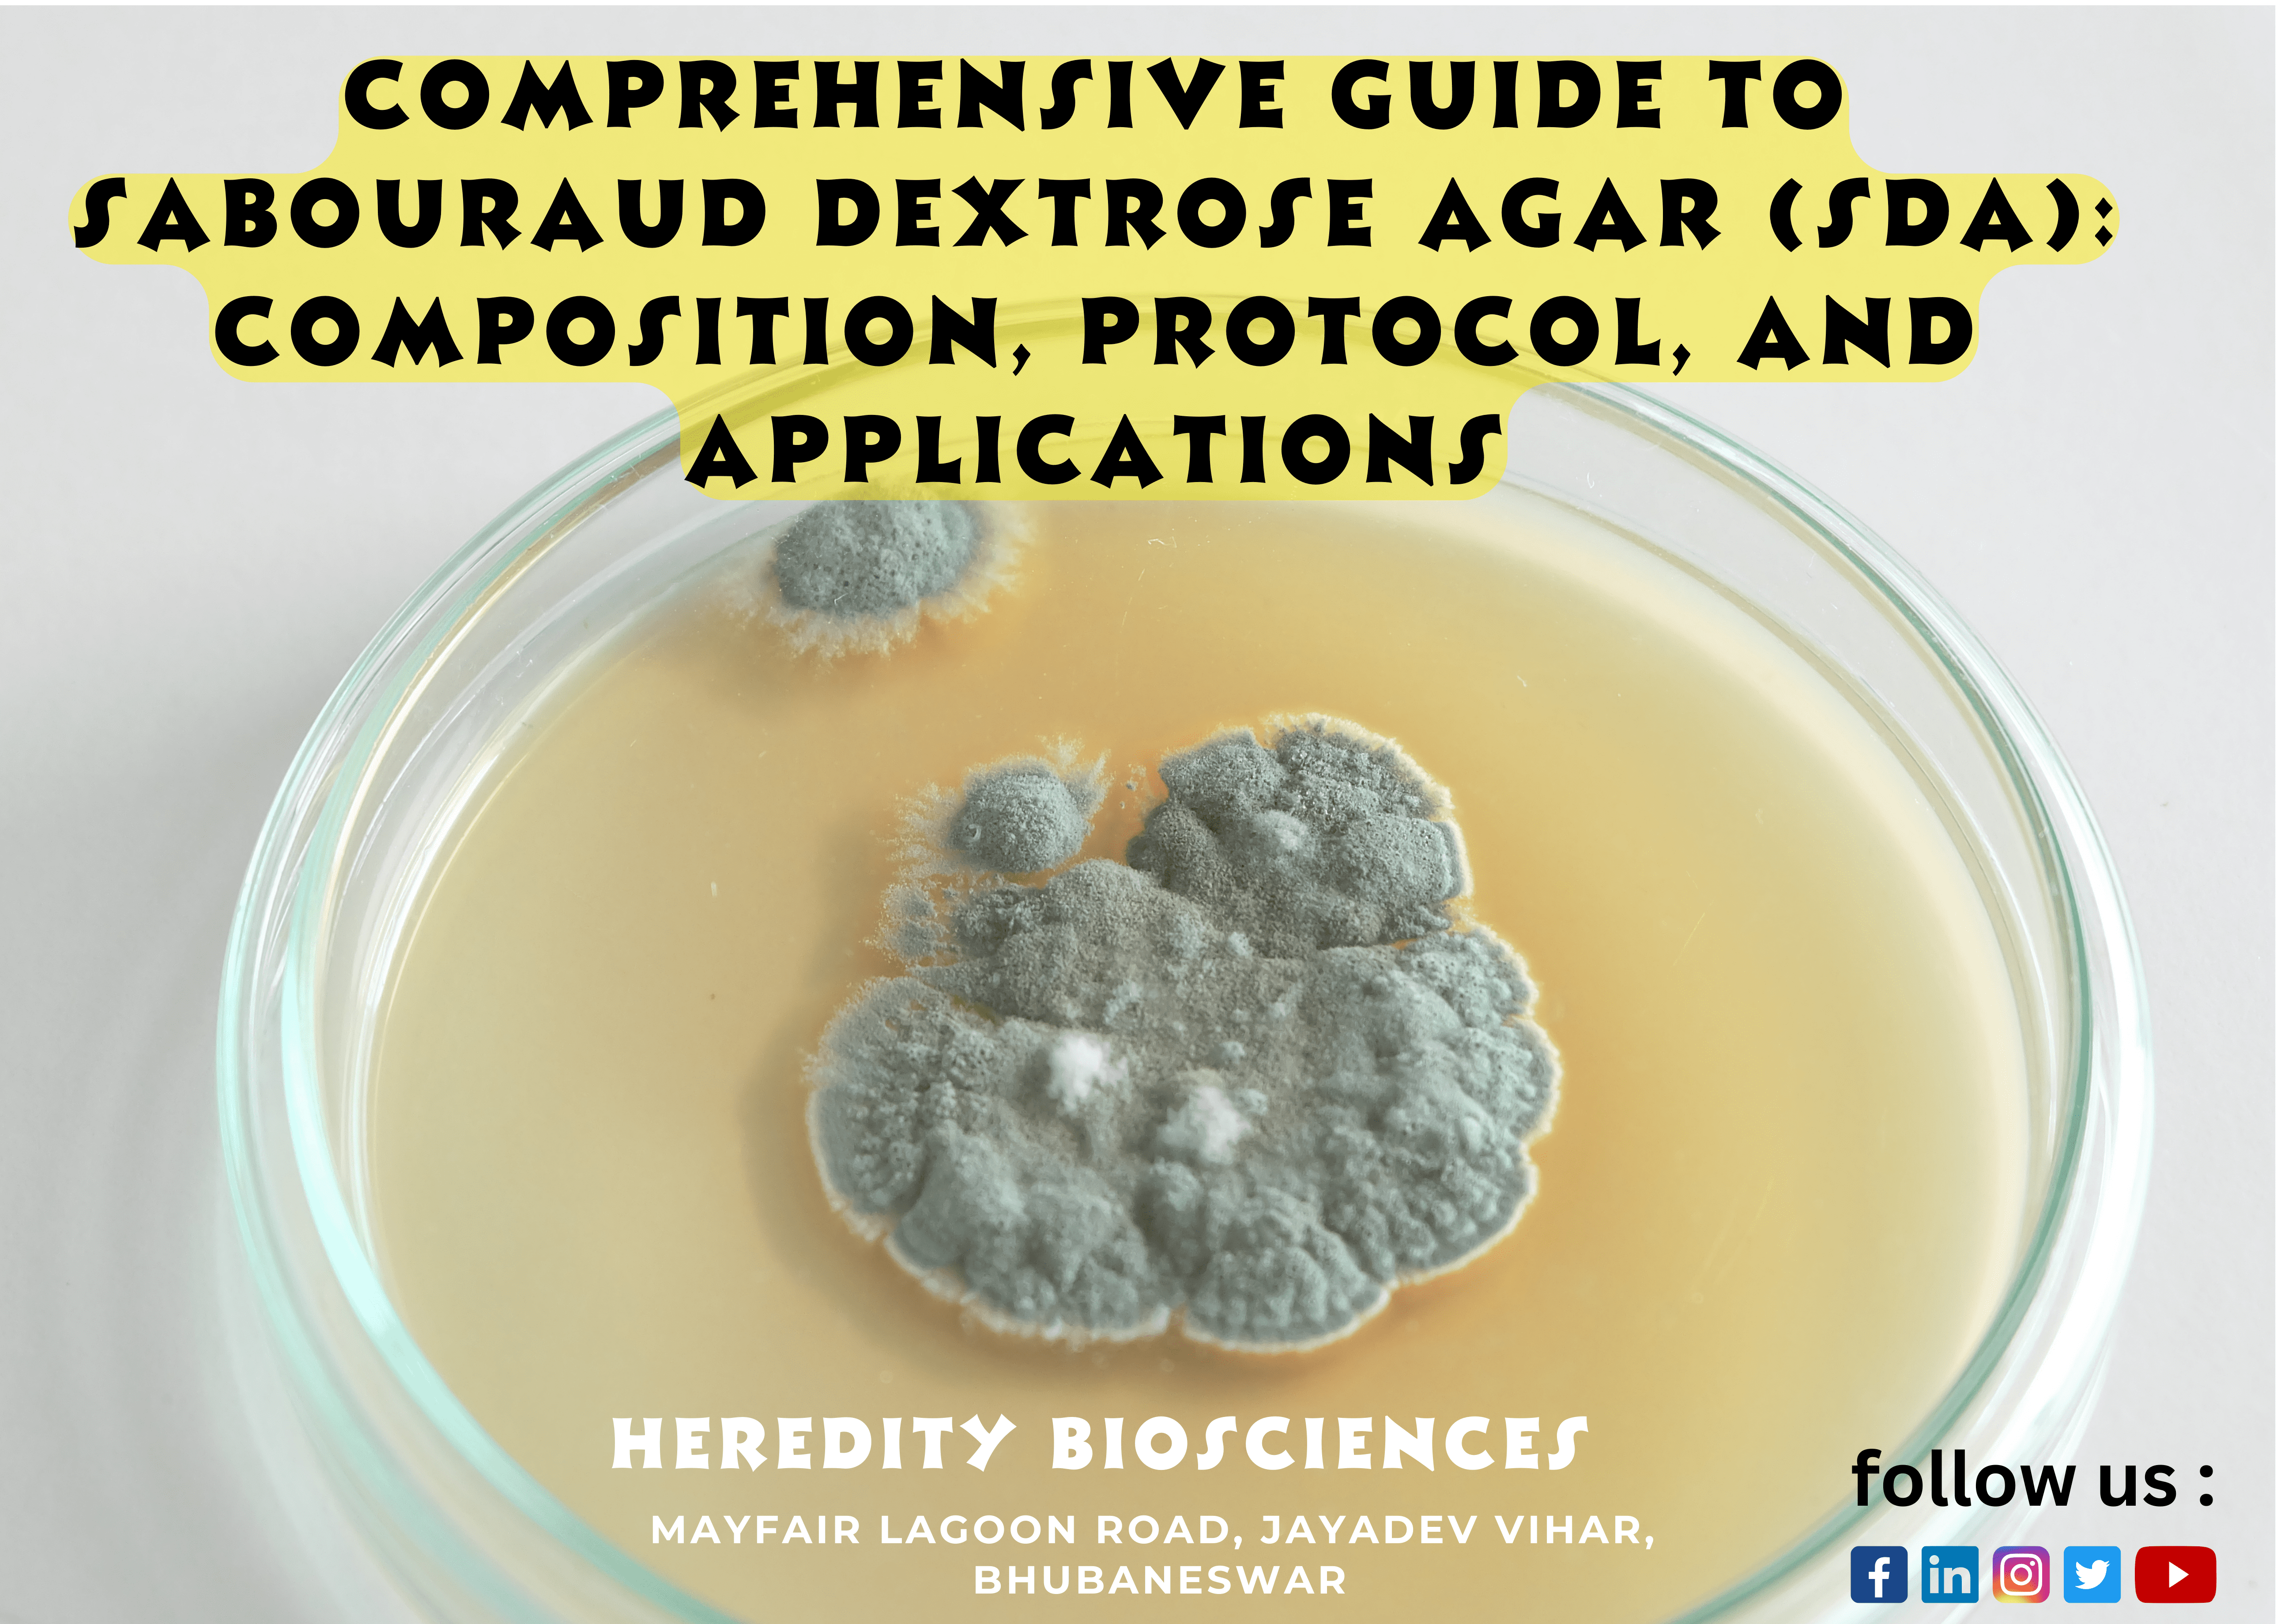
You are currently viewing Comprehensive Guide to Sabouraud Dextrose Agar (SDA): Composition, Protocol, and Applications

Heredity Biosciences, Bhubaneswar
Sabouraud Dextrose Agar (SDA) is a type of agar medium used in microbiology for the cultivation of fungi. It’s named after the French dermatologist and mycologist Raymond Sabouraud, who developed it in the late 19th century. SDA contains specific ingredients that promote the growth of fungi while inhibiting the growth of bacteria, making it a selective medium for fungi.
The composition of Sabouraud Dextrose Agar typically includes:
- Dextrose (Glucose): Provides a carbon source for fungal growth.
- Peptone: Provides nitrogenous compounds and other nutrients required for fungal growth.
- Agar: Solidifying agent that forms the gel-like structure of the agar medium.
- pH Indicator (optional): Some formulations may include a pH indicator like Phenol Red to indicate pH changes in the medium.
Preparation of Sabouraud Dextrose Agar involves the following steps:
- Weighing and mixing: Measure and mix the appropriate quantities of dextrose, peptone, and agar according to the specific recipe or manufacturer’s instructions. Dissolve these ingredients in distilled water by heating and stirring.
- Adjusting pH (if necessary): The pH of the medium should typically be adjusted to around 5.6 to 6.8, which inhibits bacterial growth and promotes fungal growth. This pH adjustment is usually done using acids (like hydrochloric acid) or bases (like sodium hydroxide).
- Autoclaving: Sterilize the medium by autoclaving it at high pressure and temperature to kill any existing microorganisms. After autoclaving, the medium is poured into Petri dishes or other containers in a sterile environment (like a laminar flow hood) and allowed to solidify.
- Storage: Once solidified, the agar plates or containers can be stored in a cool, dark place until ready for use. It’s important to store them properly to prevent contamination before use in experiments or training.
Hands-on training with Sabouraud Dextrose Agar would likely involve learning the preparation steps, understanding the specific components, practicing aseptic techniques to pour the medium into plates without contamination, and observing the growth of various fungal species under controlled conditions.
For Heredity Biosciences’ hands-on training, they might have specific protocols or variations for using SDA based on their research focus or methodologies. Always follow their provided guidelines and protocols for the most accurate results and safety measures during the training.
#sabourauddextroseagar #sda #microbiology #mycology #fungalculture #laboratoryprotocol #culturemedia #microbiologylab #lifesciences #biotechnology #labtraining #microbiologytechniques #researchlab #clinicalmicrobiology #fungalidentification #candida #aspergillus #culturemedia #labskills #scienceeducation #hereditybiosciences #diagnostics #researchtraining